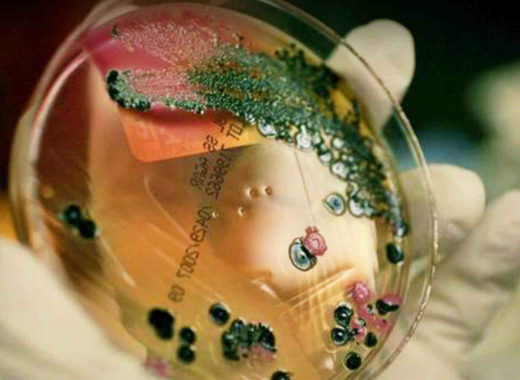

¿Qué es la salmonella bacteriana, la enfermedad que mató a Aníbal Chávez?
El alcalde de Sabaneta-Barinas y hermano del fallecido presidente Hugo Chávez Frías, Aníbal Chávez, murió la mañana de este 17 de julio en el Hospital Militar debido a complicaciones estomacales, específicamente por una consecuencia derivada de la bacteria Salmonella.